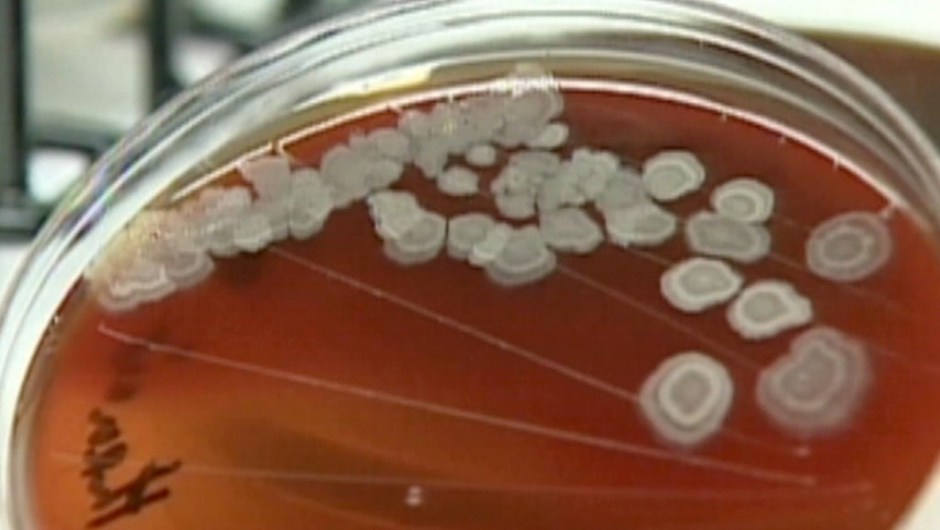
Post thumbnail

Reino Unido, Canadá y Australia reciben ántrax vivo desde el Pentágono
El Reino Unido se ha unido a la lista de países que involuntariamente recibieron envíos de muestras de ántrax vivo desde el Pentágono. Sin embargo, las autoridades británicas dijeron que las muestras,...
El Reino Unido se ha unido a la lista de países que involuntariamente recibieron envíos de muestras de ántrax vivo desde el Pentágono.
Sin embargo, las autoridades británicas dijeron que las muestras, de 2007, ya no eran una amenaza.
“No creemos que exista ningún riesgo para la salud del personal o hacia el público”, dijo el ejecutivo de Salud y Seguridad del Reino Unido, en un comunicado, señalando que la empresa en cuestión –no nombrada– ha estado en contacto con el Departamento de Defensa sobre el asunto.
Corea del Sur, Australia y Canadá también recibieron muestras de ántrax cuestionables, junto con 19 estados y el Distrito de Columbia, Estados Unidos.
El subsecretario de Defensa, Robert Work, dijo la semana pasada que espera que el número de laboratorios que se sospecha que recibieron ántrax vivo suba mientras el Pentágono continúa la investigación sobre los envíos, algunos de ellos hechos a través de FedEx.
Cuando fueron enviados por correo, no se creía que tuvieran muestras vivas de la enfermedad.
“Sabemos que no hay riesgo para el público en general de estas muestras”, enfatizó Work.
Los cuatro laboratorios del Departamento de Defensa que almacenaban muestras de ántrax para su investigación pondrán a prueba todas las muestras previamente “inactivas” para asegurar que el ántrax esté, en efecto, muerto. El departamento está probando cerca de 400 lotes, con el ántrax vivo encontrado hasta ahora.
“Es por eso que los números podrían subir “, dijo Work , y agregó que se necesitan 10 días para analizar las muestras de ántrax.
El Pentágono investigará por qué las muestras de ántrax no fueron eliminadas adecuadamente antes de ser enviadas y qué protocolos y procedimientos fallaron en el proceso.
La Agencia de Protección de la Fuerza del Pentágono, la policía del Pentágono, es una de las agencias que recibieron cuestionables envíos del Ejército estadounidense de ántrax. Ese cargamento ahora debe ser probado para ver si tiene patógenos vivos o muertos.
La policía del Pentágono recibió un cargamento de lo que se suponía era ántrax muerto de uno de los tres lotes originales, todos los que ahora parecen contener el virus vivo.
CNN











